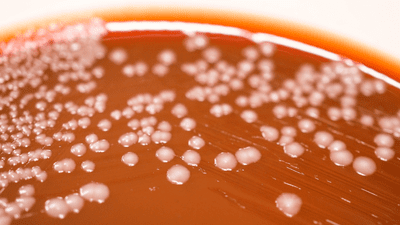

We’re currently experiencing a pandemic of fungal fascination, as each week millions of people are tuning into The Last Of Us, the TV adaptation of a game of the same name. In it, the world falls to a fungal pathogen that creates zombies capable of biting other humans and spreading the disease. We discover the fungus got into the global flour supply, and that's how it spread. And it was all made possible thanks to climate change.
The rest of this article is behind a paywall. Please sign in or subscribe to access the full content.In the opening sequence to the series, “Dr Newman” posits the idea that fungal infections could become a bigger threat to human health under climate change as rising temperatures could push them to adapt to survive in hotter environments. This would be bad for ectothermic animals like us, as currently one of the things stopping fungal infections from taking hold in healthy people is our high basal body temperature.
Now, new research using rodent models has explored how a fungal pathogen responds to environmental stressors like high temperatures, finding that it contributes to rapid evolution in a type of yeast that can launch a fatal infection. Not only can the fungus adapt in the environment, but also during infection.
The fungus in question is Cryptococcus neoformans, a type of yeast that can infect plants and animals and is commonly found in bird poop. It’s found across the planet and gets inside the human body as people breathe in its microscopic spores.
Most of the time, people exposed to C. neoformans don’t get sick, but people with compromised immune systems can fall ill. Severe infections can lead to cryptococcal meningitis where the fungus spreads to the lining of the brain, which can be fatal without treatment.

“Rising global temperatures and climate change are predicted to increase fungal diseases in plants and mammals,” wrote the study authors. “However, the impact of heat stress on genetic changes in environmental fungi is largely unexplored.”
To look into it, they used mouse models to investigate how the fungus behaved after growing at higher temperatures both in the environment and during an active infection.
Their results revealed that hot fungi exhibited more transposon copies compared to fungi grown in cooler conditions. These small segments of DNA can create or reverse mutations as they hop along the genome, potentially having a significant influence on an organism’s capacity to mutate and evolve to survive in changing environmental conditions, which could include the human body.
“This report provides a genome-wide assessment of heat stress-induced transposon mobilization in the human fungal pathogen Cryptococcus,” concluded the authors. “Transposon copies accumulated in genomes more rapidly following growth at the higher, host-relevant temperature.”
“Additionally, movements of multiple elements were detected in the genomes of cryptococci recovered from infected mice. These findings suggest that heat stress-stimulated transposon mobility contributes to rapid adaptive changes in fungi both in the environment and during infection.”
C. neoformans is a far throw from Ophiocordyceps, the zombie fungus, so won’t be giving rise to armies of clickers should it see an uptick in human infection. However, if temperatures continue to consistently soar, they could soon present another threat to human health that the world, frankly, could do without right now.
The study was published in the journal Microbiology.
[H/T: The Independent]